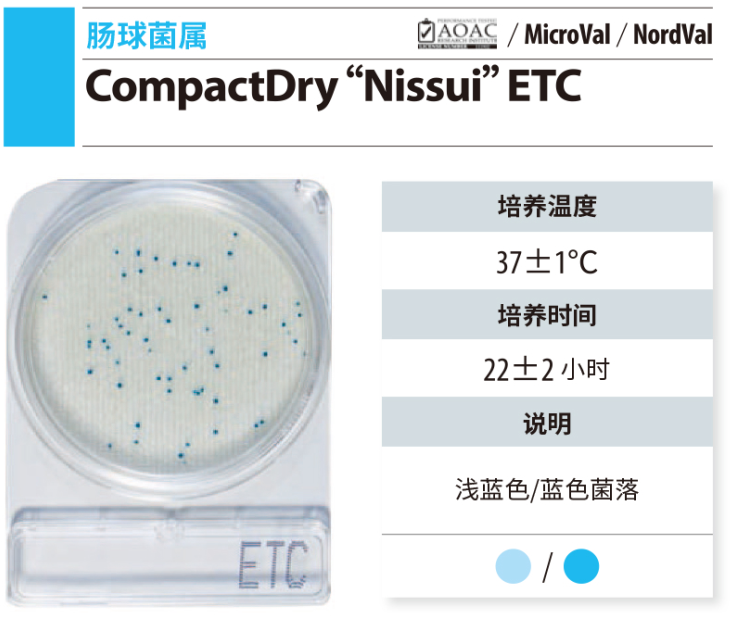
CompactDry 微生物快速测试片-2

岛津|shimadzu|Compact Dry ETC 1400pc|货号 54056|1400片(350*4pc/小包)
岛津|shimadzu|Compact Dry LS 1400pc|货号 54060|1400片(350*4pc/小包)
岛津|shimadzu|Compact Dry LS 240pc|货号 54060-240|240片(60*4pc/小包)
岛津|shimadzu|Compact Dry PA 1400pc|货号 54062|微生物快速测试片|1400片(350*4pc/小包)
岛津|shimadzu|Compact Dry PA 240pc|货号 54062-240|微生物快速测试片|240片(60*4pc/小包)

报价:面议
已咨询569次土壤/生态仪器
报价:面议
已咨询67次其他
报价:面议
已咨询67次其他
报价:面议
已咨询98次其他
报价:面议
已咨询194次1300℃-1500℃箱式炉(SiC)
报价:面议
已咨询216次1300℃-1500℃箱式炉(SiC)
报价:面议
已咨询182次1300℃-1500℃箱式炉(SiC)
报价:面议
已咨询202次1300℃-1500℃箱式炉(SiC)
货号:NCS192824-1 规格:50g 单位:瓶 浓度:见证书 适用标准:
货号:NCS192824-2 规格:50g 单位:瓶 浓度:见证书 适用标准:
货号:NCS192824-3 规格:50g 单位:瓶 浓度:见证书 适用标准:
货号:NCS192590-1 规格:50g 单位:瓶 浓度:见证书 适用标准:
货号:NCS191936-1 规格:50g 单位:瓶 浓度:见证书 适用标准:
货号:NCS191936-2 规格:50g 单位:瓶 浓度:见证书 适用标准:
货号:NCS191936-3 规格:50g 单位:瓶 浓度:见证书 适用标准:
货号:NCS192740-1 规格:50g 单位:瓶 浓度:见证书 适用标准: